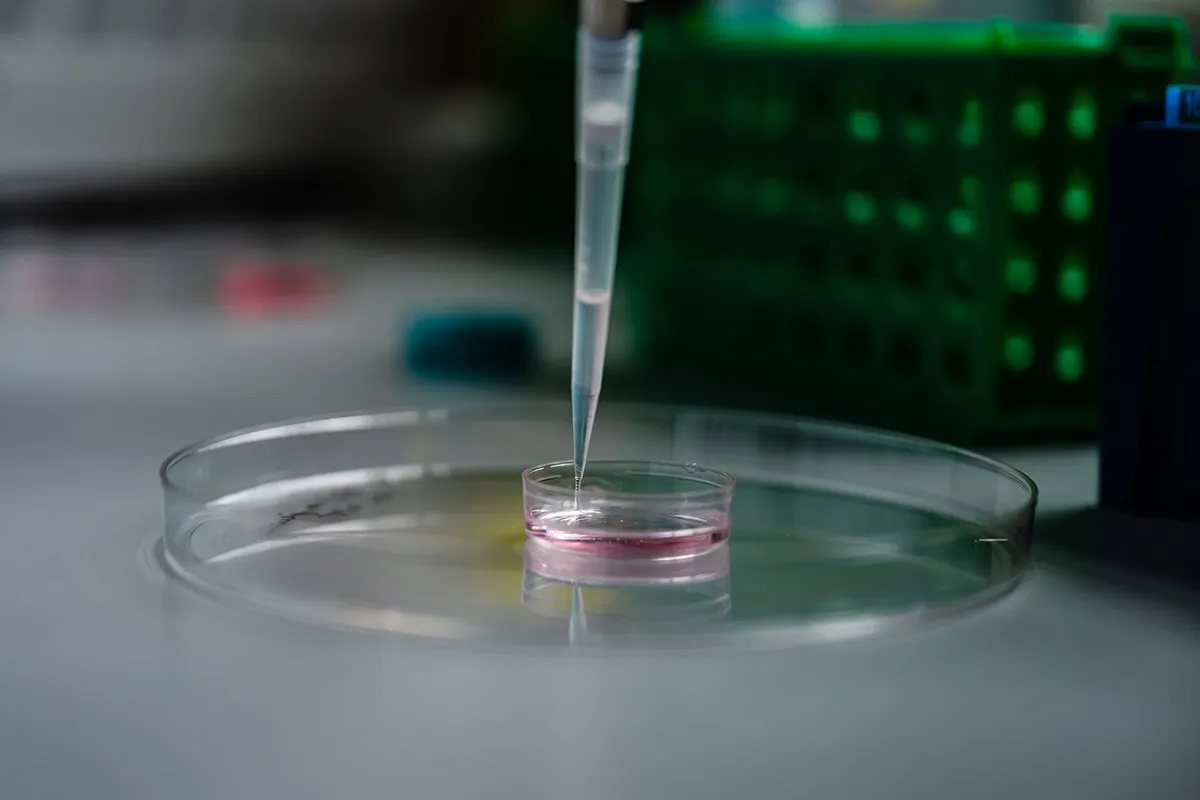

Abdou Rachid Thiam Cell organelles from a physics perspective
CNRS researcher, head of the “Biological Emulsions” group at Laboratoire de Physique de l'École Normale Supérieure, Paris
- 2025 • Liliane Bettencourt Prize for Life Sciences



Abdou Rachid Thiam develops and applies tools from physics to study how organelles function. Among these cellular compartments, he is particularly interested in lipid droplets. His multidisciplinary work, at the crossroads of physics and biology, has revealed how cells dynamically reorganise their organelles in response to variations in lipid and energy levels.
Lipid droplets
Eukaryotic cells have different compartments called organelles, each surrounded by a lipid membrane and performing a specific function. These organelles include nucleus, mitochondria and lipid droplets. Lipid droplets are the cell's main lipid reservoirs, forming during periods of energy storage. They consist of an oil droplet surrounded by a layer of phospholipids, similar to oil-in-water emulsions. They play a major role in cell membrane dynamics, interact with other organelles such as the endoplasmic reticulum, mitochondria and lysosomes, and are almost always involved in metabolic and infectious diseases, as well as cancer.
The contribution of physics to the study of organelles
Throughout his career, Abdou Rachid Thiam has adopted an interdisciplinary approach to studying organelles, with a particular focus on lipid droplets. He uses biophysical techniques such as micromanipulation and microfluidic formulation to accurately measure the physical and biochemical properties of these droplets. More specifically, he seeks to understand how they form and how specific proteins recruited at their water-oil interface regulate cell metabolism. The synergy between physicists and biologists within his team has revealed how cells reorganise their organelles in response to variations in lipid and energy levels. His recent work sheds light on the link between lipid droplets and pathologies such as lipodystrophy, infectious diseases, hepatic steatosis, type 2 diabetes, and cardiovascular disease.
A promising interdisciplinary approach
Abdou Rachid Thiam is currently focusing his research on the study of lipid homeostasis, which relies on a delicate balance between production, absorption, circulation, storage and elimination of lipids within cells. Any disruption to this process leads to disorders such as dyslipidemia, neurodegeneration and atherosclerosis.
Keen to provide concrete solutions, he founded Oria Bioscience in 2024, a start-up that develops methods for isolating organelles for therapeutic purposes. Through his approach, at the crossroads of physics and biology, Abdou Rachid Thiam's work opens up promising prospects in various sectors of medicine, with relevant tools that can be used in the field of cosmetics.
Abdou Rachid Thiam in a few words
Abdou Rachid Thiam holds a degree in physics engineering from ESPCI Paris and UPMC, and completed his postdoctoral research at Yale University. Since 2014, he has led a multidisciplinary research team at the École Normale Supérieure (ENS) exploring the biophysics and cell biology of lipid droplets and their communication with other organelles. He is actively involved in promoting science, particularly in disadvantaged communities in France and Senegal.
The originality of his approach has been recognised by his appointment as a member of EMBO in 2025 and by numerous awards, including the CNRS Bronze Medal in 2020, the Claude Paoletti Prize in 2018, and the Thomas E. Thompson Prize from the Biophysical Society in 2022.

-
2018 Claude Paoletti Prize
-
2020 CNRS Bronze Medal
-
2022 Thomas E. Thompson Prize from the Biophysical Society
-
2025 Liliane Bettencourt Prize for Life Sciences